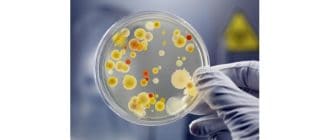

ウィートグラスは、小麦と密接に関連している草です。干し草やわらのように見える、厚くて乾いた草です。それは世代のために自然と全体的な医学の役割を果たしてきました。 Wheatgrassは発芽後通常7〜10日後に完全な大きさ […]
ミルクシスルは、さまざまな健康状態を治療するための自然療法として使用されています。しかし、ミルクシスルの健康上の利点は証明されていますか? ミルクシスルの有効成分はシリマリンと呼ばれています。ミルクシッスルはメアリーシス […]
抵抗運動と並行してホエーを補給として使用し、筋タンパク質の合成を改善し、筋肉量の増加を促進します。しかし、それは何ですか?それを使用する利点は何ですか? ミルクは、カゼインとホエーの2つのタンパク質でできています。乳清タ […]
非ステロイド系抗炎症薬(NSAID)は、痛みや炎症を和らげるのに役立ちます。しかし、副作用を引き起こしたり、特定の条件と相互作用して、代替手段が望ましくない反応が少なくても同じ鎮静効果を達成する可能性があることを意味しま […]
拡張期および収縮期という用語は、心筋が弛緩および収縮するときを指す。拡張期と収縮期との間のバランスは、人の血圧を決定する。 心臓は、体のすべての組織や器官に酸素が豊富な血液を供給するポンプです。心拍は、心筋が弛緩し収縮す […]
リンパ球は、体の主要な免疫細胞の一つでもある白血球である。それらは骨髄で作られ、血液やリンパ組織に含まれています。 免疫系は、リンパ球を含む免疫細胞として知られる複雑な細胞ネットワークである。これらの細胞は、その機能を脅 […]
乳房塊は、その周りの乳房組織または他の乳房の同じ領域の乳房組織とは異なる感じの、乳房内の局部的な腫脹、隆起、膨らみ、または隆起である。 乳房瘤が発症するさまざまな理由があります。ほとんどの塊はがん性ではありません。 原因 […]
細菌は、何百万人にも、あらゆる環境において、他の生物の内部および外部に存在する微視的な単細胞生物です。 いくつかの細菌は有害であるが、大部分は有用な目的に役立つ。彼らは植物や動物のいろいろな生活様式をサポートしており、工 […]
アデノイドは、扁桃の上の喉の後部に位置する組織の小さな塊である。扁桃腺と一緒に、幼児や幼児の防御の第一線を形成します。彼らは体内に入ってくる細菌やウイルスをサンプリングするためです。 このように、アデノイドは、身体が傷害 […]
月経や月経は、子宮の内面の脱落です。月経は月経としても知られています。月経は、生殖年齢の間、女性のための正常な性的健康の一部です。 膣からの出血を含む月経は、主に霊長類などのヒトおよび類似の動物の間で見出される。 子宮内 […]
火のアリは、幸せな午後を貧しい人々の苦痛の痛ましい流れに変えることができます。火災蟻の攻撃は、通常、瞬間的な激しい痛みを引き起こします。痛みはすぐにかゆみや皮膚の炎症につながり、数時間から数日間は持続します。 火のアリは […]
植物エストロゲンは、植物や植物由来の食品に含まれる天然化合物です。食べると、身体によって産生されるエストロゲンと同じように人に影響を与える可能性があります。 この記事では、植物エストロゲンの健康上の利点とリスクについて説 […]
女性の顔の特徴は男性の女性らしいと解釈されますが、難しい特徴はより男性的なものとみなされますか?英国のセントアンドリュース大学の研究者による新しい調査によると、必ずしもそうとは限りません。この調査では、男性は、身長がより […]
催眠幻覚は非常に現実的であると想像される感覚です。人が眠っているときに発生し、睡眠幻覚とも呼ばれます。 hypnopompicという用語は、人が目を覚ます時を表しています。催眠術は、人が眠っている期間を定義します。 幻覚 […]
安楽死と医師が自殺した自殺とは、永続的な苦痛を和らげるために、人生を終わらせるという意思で行われた意図的な行動を指します。 ほとんどの国で安楽死は法律に違反しており、刑務所に処刑される可能性があります。米国では、州によっ […]
コンドームは、障壁を形成し、精子が卵を受精させるのに要する経路を遮断することによって働く、出生抑制の方法である。また、性感染症の伝染を防ぐのに役立ちます。 コンドームを使用すると、HIV /エイズ、淋病、クラミジア、梅毒 […]
関節リウマチは、身体の免疫系が関節を繋ぐ健康な組織を攻撃する炎症性関節炎の一種です。生物製剤は、これらの健康な組織を攻撃している免疫細胞と戦うように設計されています。 関節リウマチ(RA)は、関節の痛み、腫れ、および変形 […]
すべての生き物には遺伝子があります。彼らは全身に存在します。遺伝子は、生物がどのようなものであるか、その外観、生き残る方法、およびその環境においてどのように行動するかを決定する一連の命令である。 遺伝子は、デオキシリボ核 […]
アレルギー性のシャイナー(アレルギー性顔面または眼窩周囲静脈鬱血とも呼ばれる)は、アレルギーの症状です。彼らは目の下の暗い円として現れ、傷や「黒い目」に似ています。 アレルギー性のシャイナーは、鼻腔内の組織の腫脹のために […]
蕁麻疹は、時にはアレルゲンによって誘発される赤い、隆起したかゆみの皮膚の発疹です。アレルゲンは、アレルギー反応を引き起こすものです。 それは、蕁麻疹、皺、咬傷、または痒疹としても知られています。 アレルギー反応が起こると […]
リウマチ様小結節は、皮膚の下に発生する硬い塊である。これらはリウマチ性関節炎に特有の症状であり、通常、その状態の影響を受けた関節の近くで起こる。 慢性関節リウマチ患者の約4分の1がリウマチ様結節を発症する。彼らは伝染性で […]